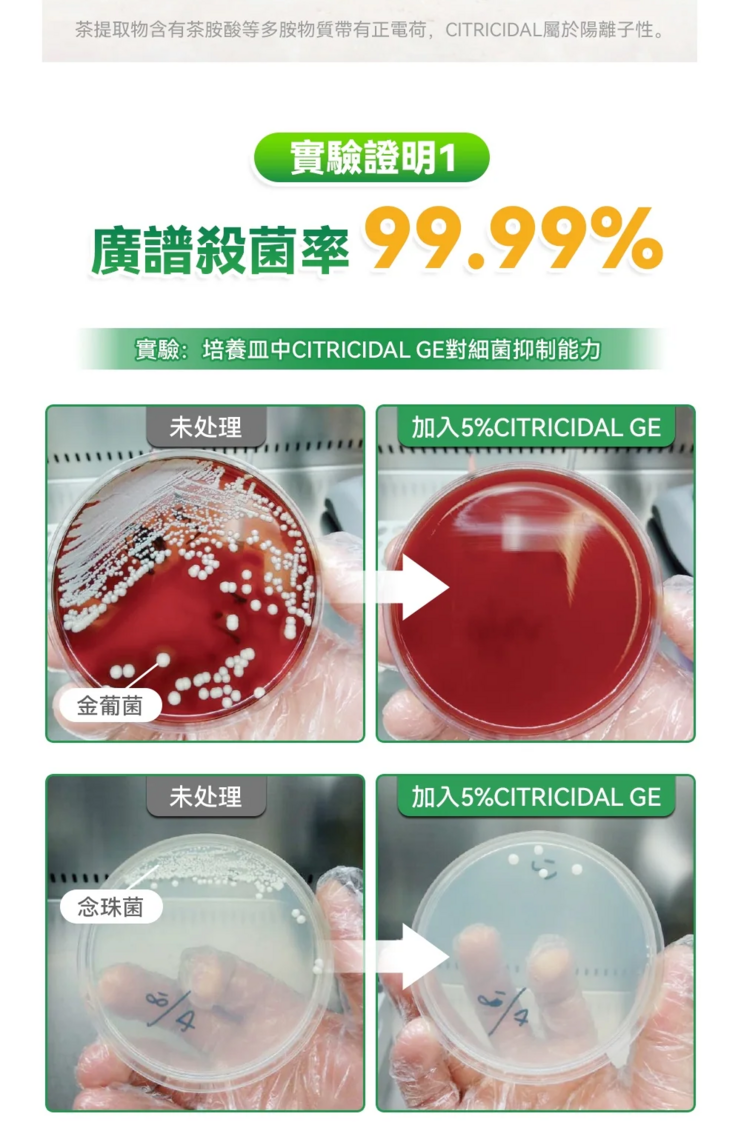

1.品牌:Healthive
2.產品名稱:日本Healthive專研3倍抗菌脫臭植萃修護腳氣水
3.產品售後:香港、澳門
4.產品保養:1年
5.產品產地:日本品牌,中國製造
6.淨重:0.13kg
7.產品尺寸:43*156mm
8.適用人群:13歲以上人群可用、哺乳期可用
9.禁忌人群:有開放性傷口或其他皮膚疾病建議不使用、孕婦暫不建議使用
10.使用位置:腳底、腳掌、腳趾等、鞋襪也可用
11.保質期限:3年(開封後請在一年內使用完畢,使用完保持產品密封)
12.外用:早晚各一次,也可酌情增減;嚴重部位可多噴幾次
13.使用週期:首次開始使用至少持續使用15日;腳氣輕中症程度-持續15-30日後,逐漸減少用量;腳氣嚴重程度-建議至少以3個月為一個療程。以上均需因個人生活環境和習慣而有所差異,且腳氣屬於容易反復的問題,如長期足底在潮濕高熱環境,使用本品可相對減少氣味和足底症狀,建議持續使用。
1.獨家定制三重殺菌抑菌除腳臭配方,CITRICIDALX尿囊素X茶提取物,三重天然抗菌。
2.使用方便,噴後速乾,並在足底形成抑菌防護膜,高效抑菌,源頭分解異味,達到有效防臭。
3.100%天然植萃配方無刺激性,不產生依賴性,完成相應產品檢測和有效體驗,使用安全放心。
4.升級添加角質修復/抗炎/保濕舒緩成分,除臭同時減少足底角質,恢復足部嫩滑肌膚。
5.不限使用位置,足底、小腿、鞋子、鞋櫃等位置都適用,全方位聯合殺菌。

日本Healthive|專研3倍抗菌脫臭植萃修護腳氣水
數量